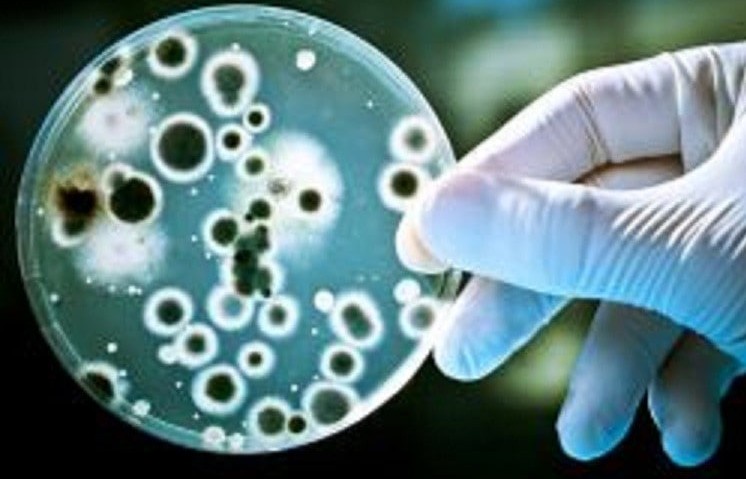

Ташкилот бош директори Тедрос Гебреесуснинг таъкидлашича, охирги бир йил ичида дунёда холера вабосига чалиниш ҳолатлари кескин кўпайган. Биргина жорий йилнинг ўтган тўққиз ойида 27 мамлакатда ушбу касаллик эпидемияси кузатилиб, кўплаб беморлар ҳаётдан кўз юмган.
Масалан, Сурияда сўнгги олти ҳафтада 10 минг нафардан ортиқ киши мазкур хавфли инфекцияга гумон қилинган.
Покистонда эса 1 500 дан ортиқ одамнинг ҳаётига зомин бўлган даҳшатли сув тошқинларидан кўп ўтмай холера вабоси авж олди. Агар шошилинч чоралар кўрилмаса, яқин ҳафталарда яна кўплаб одамлар хасталик қурбонига айланиши мумкин.
«Холера оқибатида беморлар ҳатто бир неча соат ичида жон таслим қилишлари мумкин, — дейди ЖССТ раҳбари. — Шунга қарамай, замонавий тиббиёт махсус муолажалар орқали хасталикни даволаш имкониятига эга. Касалликка қарши вакциналар эса вабо профилактикасида энг самарали чора.
Бироқ дунёнинг баъзи мамлакатлари аҳолиси шундан ҳам бебаҳра. 2013 йилда ҳамкорларимиз холерага қарши вакциналарнинг халқаро захирасини яратганди. Аммо улар эпидемиянинг олдини олиш учун етарли эмас. Шу боис, бу борада шошилинч чоралар кўришимиз зарур».
Мутасаддининг фикрича, жаҳонда бу йил турли эпидемиялар оқибатида содир бўлаётган ўлим ҳолатлари беш йил аввалги кўрсаткичга нисбатан деярли уч баравар ошганидан барчамиз тўғри хулоса чиқариши зарур.
Эслатиб ўтамиз, холера вабоси ингичка ичакнинг зарарланиши, интоксикация, умумий аҳвол оғирлашуви ва организм сувсизланиши билан кечадиган ўта хавфли ўткир инфекцион касаллик ҳисобланади, деб хабар беради Соғлиқни сақлаш вазирлиги матбуот хизмати.